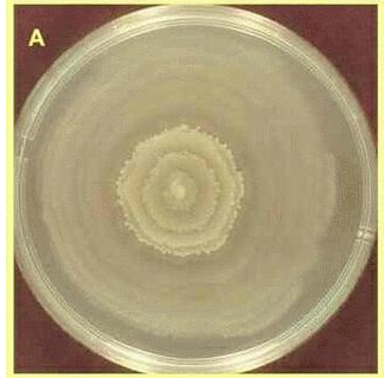
<p></p>
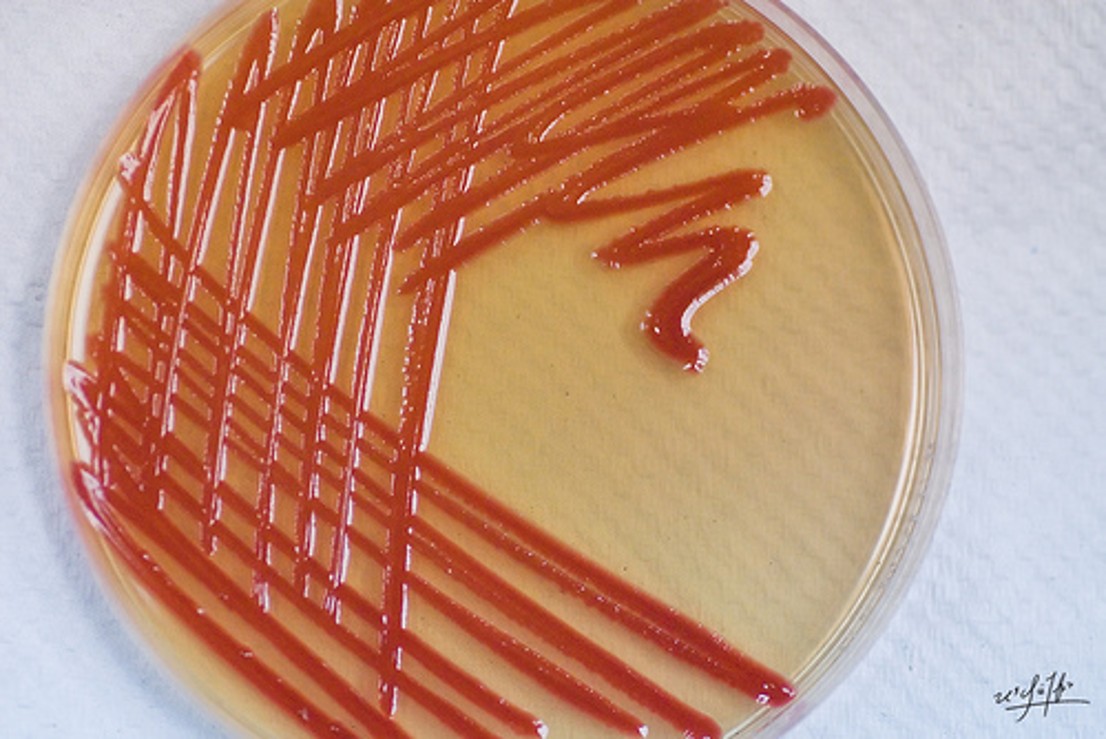
<p></p>
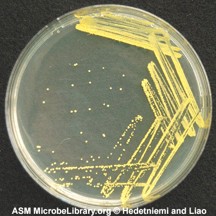
<p>produces bright yellow colonies; most common even in clean rooms</p>
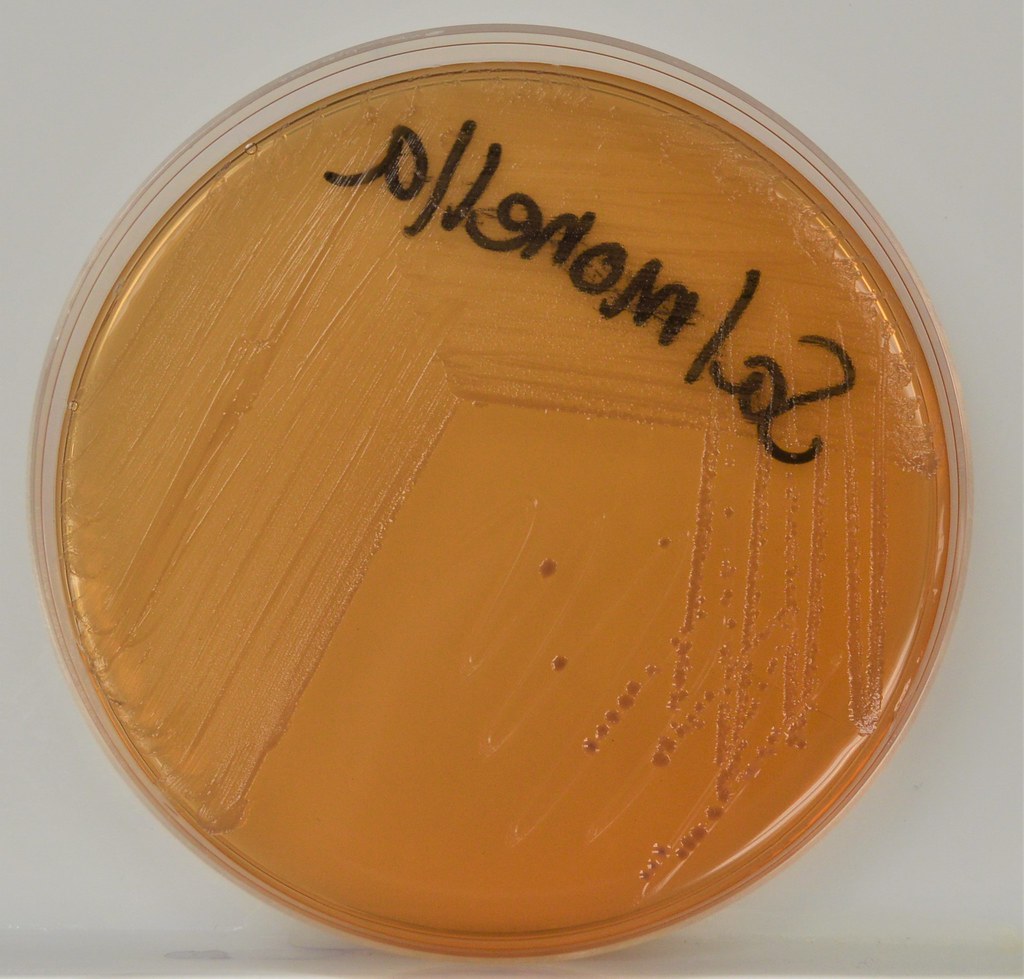
<p><span>The organism growing on this MacConkey Agar plate is growing but the color of agar has not changed appreciably.&nbsp; Which of the following is the best interpretation of these results?</span></p>
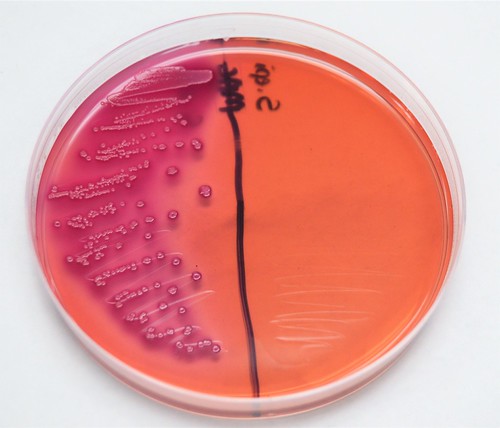
<p>The left side of the MacConkey Agar plate shown above shows an organism&nbsp; that is __________ for ____________ fermentation.&nbsp;</p>
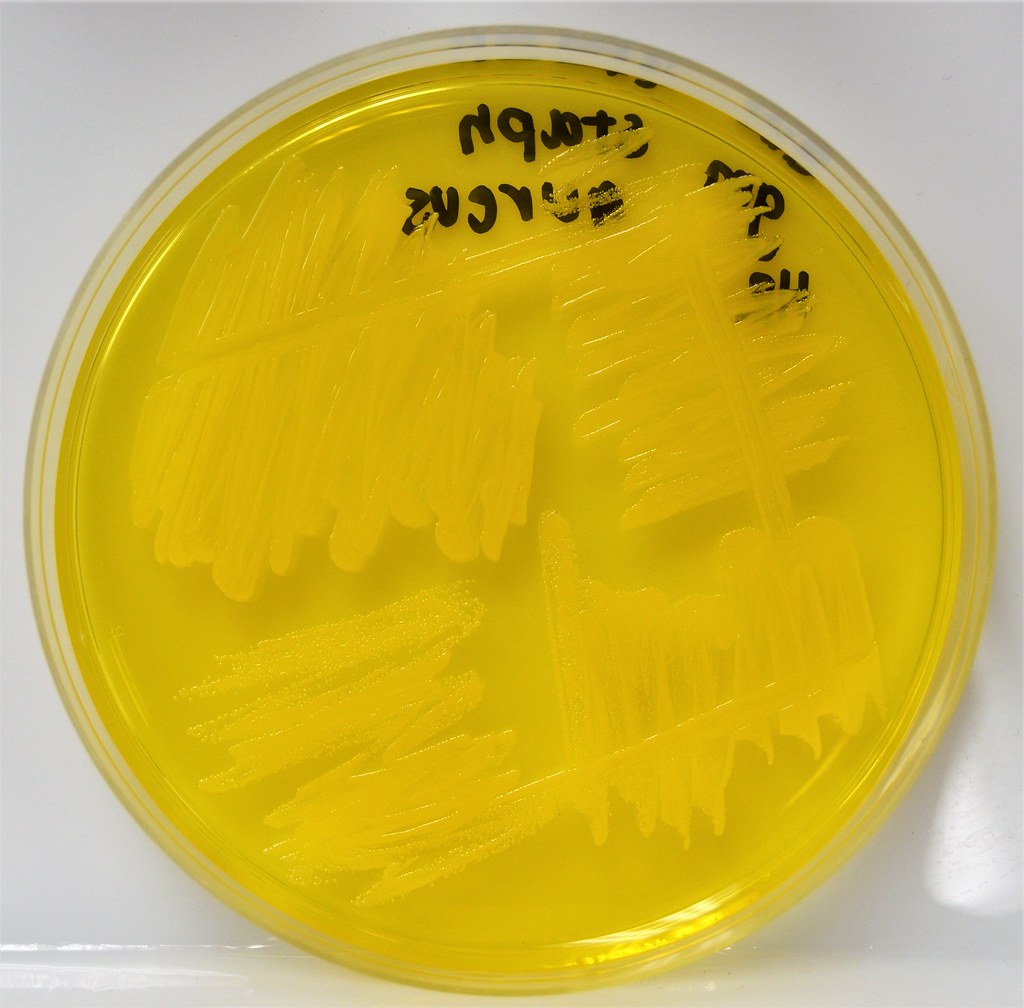
<p><span>The image above shows growth of an organism on MSA agar.&nbsp; The yellow color indicates.&nbsp;</span></p>

Micro Lab Final Exam
1/107
There's no tags or description
Looks like no tags are added yet.
Name | Mastery | Learn | Test | Matching | Spaced | Call with Kai |
|---|
No analytics yet
Send a link to your students to track their progress
108 Terms

Staphylococcus aureus, Gram positive coccus
thick peptidoglycan with thick capsule layer, antibiotic resistant
staphylococcus aureus
factors that help cells cause disease
virulence factors
Staph aureus antibiotic-resistant strains
MRSA, VRSA
Positive for?
Catalase and coagulase
What hemolysis?
Beta hemolysis on blood agar.
Proteus Vulgaris, Gram negative rod
tested on SIM agar; metabolizes catalase, indole, and reduces sulfur!!
Proteus Vulgaris
What does it cause?
Causes UTIs; highly motile/swarming
Serratia marcescens, Gram negative rod
Enterobacteriaceae family, causes UTI & Resp. infection; red pigment (prodigiosin) studied for antimicrobial & cytotoxic capabilities
Serratia marcescens

Mycobacterium tuberculosis; Gram variable rod
non-motile; cell wall made of mycolic acid, resists drugs
Mycobacterium tuberculosis
How does it function?
It is slow-growing, requires oxygen-rich environment; used for Acid Fast Stain

Escherichia coli, Gram Negative rod
faculative anaerobe, enteric; produces large amounts of catalase
E. coli
flexible, can live with or without oxygen
faculative anaerobe
produce shiga-like toxin, cell wall & flagellar antigen
E. coli serotype 0157:h7
What agar is E. coli on?
MacConkey agar

Pseudomonas aeruginosa, Gram negative rod
opportunistic pathogen found in hospitals; common for burn & cystic fibrosis pts
Pseudomonas aeruginosa
What is Pseudomonas positive for?
catalase & citrate positive
Color and Toxin?
greenish color; pyocyanin → cytotoxin

Bacillus subtilis, Gram positive rod
spore-forming bacteria found in soil, colonies form chains; most commonly studied
Bacillus subtilis
Bacillus subtilis is pos. for?
Lipase & amylase positive
What agar is used for Bacillus subtilis?
Spirit blue agar to test for hydrolyze starch

Micrococcus luteus, Gram positive coccus
produces bright yellow colonies; most common even in clean rooms
Micrococcus luteus
Micrococcus luteus formation?
Tetrad, catalase positive, and obligate aerobe.
It’s a way E. coli can gain new genetic material; traveling & picking up genes from other organisms
Transduction
selective & differential, contains crystal violet & bile salts; inhibits Gram (+) & allows Gram (-) to grow.
MAC (MacConkey Agar)
neutral red turns pink/purple, has lactose to differentiate coliforms & noncoliforms
MAC pH indicators
organism that thrives in basic environments with a pH of 9 or higher; grows best in these environments
Alkalinophile
cells intertwine like strands in a rope
Cording
mycolic acid in cell walls help cells cling together
cord factor
media that supports the growth of specific microorganisms while inhibiting others
Selective Media
methylene blue, eosin y, bile salts, & NaCl
Selective Media inhibitors
general-purpose media, does not restrict anything from growing; does not show visible differences between organisms (look the same)
Nutrient Agar
bring out differences & colors due to metabolic abilities of microorganisms to determine identification
Differential Media
Diluent
sterile water to dilute your sample
density
how many CFUs per mL
something that can combine with other substances to enhance them
catalase
Bacillus that ferments lactose; dark purple, green color
Coliforms
do NOT ferment lactose; usually lighter color & do not produce gas
Noncoliforms
gas catcher, catches CO2 bubbles
Durham Tube
selective & differential, used for environment testing; gram pos. will not grow, while gram neg. can be identified
EMB Agar
gram-negative, typically grow (coliforms & noncoliforms); show distinct colony colors based on lactose fermentation.
Eosin & Methylene Blue Agar (EMB)
used to test for hydrogen sulfide production, indole formation, and motility in bacteria.
SIM Agar
Gram-negative bacteria, coliform & noncoliform; many are gut inhibitors
Enterobacteriaceae
made of protein from animal hooves, gelatinase enzyme to break it down
Gelatin
break down tryptophan, used in SIM agar
indole
energy releasing using sulfur in place of oxygen, not all organism can reduce sulfur
oxidation of indole
if red indicates positive for acid; if yellow indicates negative, base
Methel Red
is pH indicator; has sugar to create a byproduct of acid
phenol red broth
supports the growth of fastidious organisms and allows for the detection of hemolysis.
Blood Agar
organisms that don’t grow well on nutrient agar do better on blood agar due to their specific nutrient requirements.
fastidious organisms
partial destruction of RBCs & hemoglobin (turns it GREEN color)
Alpha hemolysis
complete breakdown of RBCs & partial hemoglobin; CLEAR color
Beta hemolysis
no destruction of RBCs or hemoglobin, keeps the red stain color or no color
Gamma hemolysis
Selective & differential; form gram negative organisms
Bromthymol Blue
No blue means organisms did not grow, while yellow indicates acid production and growth of acid-producing bacteria.
pH indicator for Bromthymol Blue
used for detecting lipid hydrolysis(requires bacterial lipase); pos. result has clearing around the colonies
Spirit Blue Agar
halophiles
salt lovers
selective for genes of gram pos. halophilic cocci; salt inhibitor
Mannitole Salt Agar (MSA)
Do rods grow on MSA?
No, because of salty condition
used to test for starch hydrolysis; use bacterial amylase to do this
Starch Agar
test for Butylene glycol fermentation, detects acetoin production
Voges-Proskauer Test
VP Test results
if positive, it turns red color at top of the tube; if negative, it turns to copperish “green” color
can turn into indole if the bacteria can make tryptophanase; add reagent Kovac to turn Cherry Red
Tryptophan
Scientific Name
Capitalize the first letter of genus name, underline both genus & species
Gram Neg. Color
pink/red
Gram Pos. Color
purple
Cocci
spherical
Bacilli
Rod-shaped
Spirillum
rigid spiral
Staphlococcus
cluster of spherical bacteria
streptococcus
chain of spherical bacteria
diplococci
pairs
tetrads
groups of 4
streptobacilli
chain of rod-shaped bacteria
palisades
rod-shaped bacteria arranged side by side
spirochete
flexible, corkscrew
vibrio
comma-shaped
Selective & differential, determines if organism can use citrate as its sole carbon source; contains citrate, bromthymol blue, and ammonium phosphate
Simmons Citrate Agar
Simmons Citrate Agar Results
if blue it uses citrate to raise pH (pos. result); negative result is green
determines if organisms can use citrate as a carbon source for growth
citrate test
determines if an organism can move through a medium; pos. growth spreads away from stab lines
motility test
tests if organisms can reduce sulfur to hydrogen sulfide (H₂S); produces a black precipitate in the medium if pos.
sulfur reduction
test if organisms can ferment lactose; if pos. it turns pink/red on MAC agar & dark green on EMB agar
lactose fermentation
positive results turn yellow on MSA; organisms can ferment mannitol
mannitol fermentation
test for Staphylococcus aureus; pos. result is clot formation
Coagulase Test
detects catalase enzyme; positive result shows bubbling due to H2O2
Catalase Test
Indole, Methyl Red, Voges-Proskauer, Citrate
IMViC
Yellow MSA
acid, NOT base
Colorless MAC
there is growth, but no lactose
EMB metallic green
E. coli
The organism growing on this MacConkey Agar plate is growing but the color of agar has not changed appreciably. Which of the following is the best interpretation of these results?
The organism is a Gram-negative rod
The left side of the MacConkey Agar plate shown above shows an organism that is __________ for ____________ fermentation.
positive, lactose
The image above shows growth of an organism on MSA agar. The yellow color indicates.
the organism is fermenting mannitol